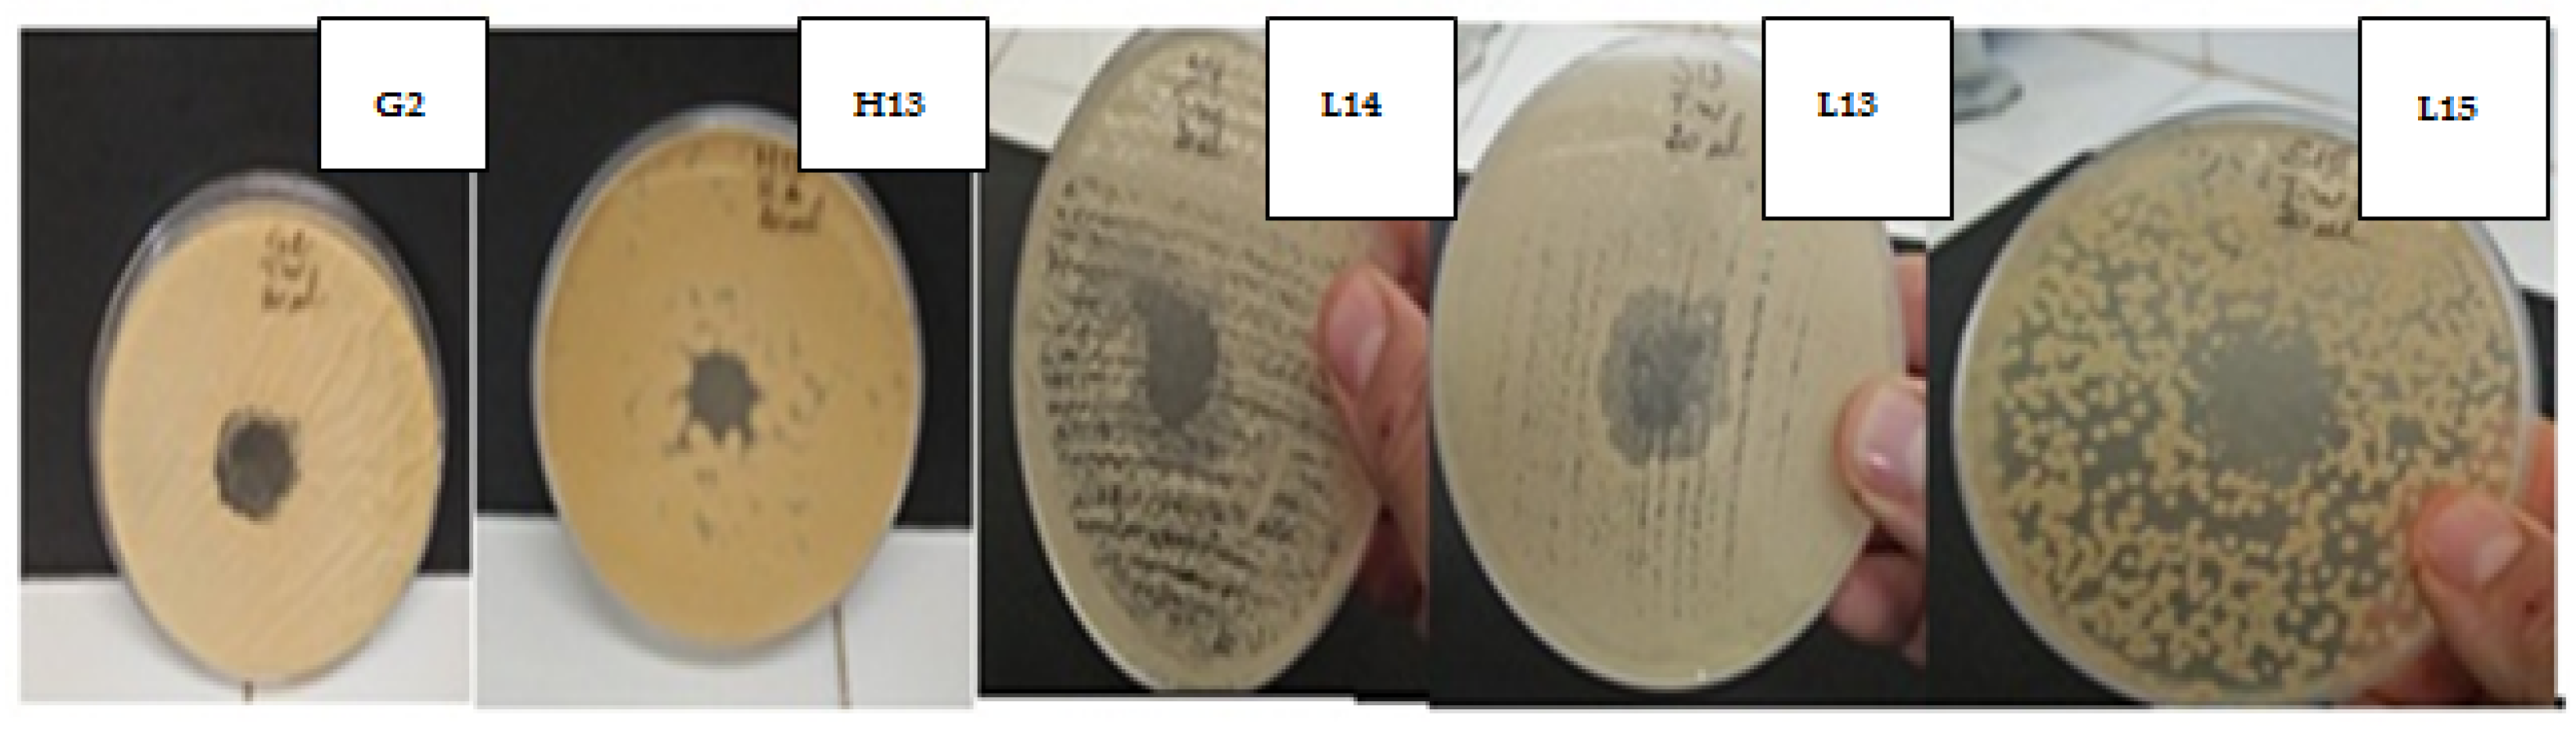
Plants 11 00015 g005 Plants 11 00015 g005

Phytochemical Analysis, Antimicrobial and Antioxidant Properties of Thymus zygis L. and Thymus willdenowii Boiss. Essential Oils
Abstract
1. Introduction
2. Results and Discussion
2.1. Phytochemical Study
The Yield of Essential Oils
2.2. Physicochemical Characteristics of the Selected Thyme Essential Oils (Density, Refractive Index, and Brix Degree)
2.3. Chemical Composition of T. zygis and T. willdenowii Essential Oils
2.4. Antioxidant Activity of the Essential Oils of the Two Thymes
2.5. Antibacterial Activity of T. zygis and T. willdenowii EOs
2.5.1. Antibiotic Sensitivity Test
2.5.2. Antibacterial Activity of T. zygis and T. willdenowii Essential Oils
2.6. Antifungal Activity of T. zygis and T. willdenowii EOs
2.6.1. Sensitivity of Fungal Strains
2.6.2. Antifungal Activity of Essential Oils
3. Materials and Methods
3.1. Plant Material
3.2. Extraction of Essential Oils
3.3. Physicochemical Analysis of the Essential Oils of the Two Thymes: Refractive Index, Brix Degree, and Density
3.4. Gas Chromatography Coupled with Mass Spectrometry Analysis of Essential Oils
3.5. Antioxidant Activity of the Essential Oils
3.5.1. DPPH Free Radical Scavenging Assay
3.5.2. Ferricyanide FRAP Assay
3.6. Antibacterial and Antifungal Activity
3.6.1. Selected Microbial Strains and Sensitivity Test
3.6.2. Disc Diffusion Method
3.6.3. Minimum Inhibitory Concentration (MIC)
3.6.4. Minimum Bactericidal Concentration (MBC) and Minimum Fungicidal Concentration (MFC)
3.7. Statistical Analysis
4. Conclusions
Author Contributions
Funding
Institutional Review Board Statement
Informed Consent Statement
Data Availability Statement
Acknowledgments
Conflicts of Interest
References
- Mechchate, H.; Es-Safi, I.; Mohamed Al Kamaly, O.; Bousta, D. Insight into Gentisic Acid Antidiabetic Potential Using In Vitro and In Silico Approaches. Molecules 2021, 26, 1932. [Google Scholar] [CrossRef]
- Es-Safi, I.; Mechchate, H.; Amaghnouje, A.; Elbouzidi, A.; Bouhrim, M.; Bencheikh, N.; Hano, C.; Bousta, D. Assessment of Antidepressant-Like, Anxiolytic Effects and Impact on Memory of Pimpinella anisum L. Total Extract on Swiss Albino Mice. Plants 2021, 10, 1573. [Google Scholar] [CrossRef]
- Boyle, W. Spices and Essential Oils as Preservatives. In American Perfumer and Essential Oil Review; Allured Publishing Corporation: Carol Stream, IL, USA, 1955; Volume 66, pp. 25–28. [Google Scholar]
- Burt, S. Essential Oils: Their Antibacterial Properties and Potential Applications in Foods—A Review. Int. J. Food Microbiol. 2004, 94, 223–253. [Google Scholar] [CrossRef]
- Bencheikh, N.; Bouhrim, M.; Kharchoufa, L.; Al Kamaly, O.M.; Mechchate, H.; Es-Safi, I.; Dahmani, A.; Ouahhoud, S.; El Assri, S.; Eto, B.; et al. The Nephroprotective Effect of Zizyphus lotus L. (Desf.) Fruits in a Gentamicin-Induced Acute Kidney Injury Model in Rats: A Biochemical and Histopathological Investigation. Molecules 2021, 26, 4806. [Google Scholar] [CrossRef] [PubMed]
- Es-Safi, I.; Mechchate, H.; Amaghnouje, A.; Jawhari, F.Z.; Bari, A.; Cerruti, P.; Avella, M.; Andriy, A.; Andriy, D. Medicinal Plants Used to Treat Acute Digestive System Problems in the Region of Fez-Meknes in Morocco: An Ethnopharmacological Survey. Ethnobot. Res. Appl. 2020, 20, 1–14. [Google Scholar] [CrossRef]
- Maksimović, Z.; Stojanović, D.; Šoštarić, I.; Dajić, Z.; Ristić, M. Composition and Radical-scavenging Activity of Thymus Glabrescens willd. (Lamiaceae) Essential Oil. J. Sci. Food Agric. 2008, 88, 2036–2041. [Google Scholar] [CrossRef]
- Richard, H.; Benjilali, B.; Banquour, N.; Baritaux, O. Etude de Diverses Huiles Essentielles de Thym Du Maroc. Lebensm. Wiss. Technol. 1985, 18, 105–110. [Google Scholar]
- Fennane, M.; Ibn-Tattou, M. Flore Pratique du Maroc, Volume 2: Angiospermae (Leguminosae-Lentibulariaceae); L’Institut Scientifique: Rabat, Morocco, 2007; ISBN 9954834745. [Google Scholar]
- Bencheikh, N.; Elbouzidi, A.; Kharchoufa, L.; Ouassou, H.; Alami Merrouni, I.; Mechchate, H.; Es-Safi, I.; Hano, C.; Addi, M.; Bouhrim, M.; et al. Inventory of Medicinal Plants Used Traditionally to Manage Kidney Diseases in North-Eastern Morocco: Ethnobotanical Fieldwork and Pharmacological Evidence. Plants 2021, 10, 1966. [Google Scholar] [CrossRef]
- Kharchoufa, L.; Bouhrim, M.; Bencheikh, N.; Addi, M.; Hano, C.; Mechchate, H.; Elachouri, M. Potential Toxicity of Medicinal Plants Inventoried in Northeastern Morocco: An Ethnobotanical Approach. Plants 2021, 10, 1108. [Google Scholar] [CrossRef] [PubMed]
- Amarti, F.; El Ajjouri, M.; Ghanmi, M.; Satrani, B.; Aafi, A.; Farah, A.; Khia, A.; Guedira, A.; Rahouti, M.; Chaouch, A. Composition Chimique, Activité Antimicrobiennne et Antioxydante de l’huile Essentielle de Thymus zygis Du Maroc. Phytothérapie 2011, 9, 149. [Google Scholar] [CrossRef]
- Panizzi, L.; Flamini, G.; Cioni, P.L.; Morelli, I. Composition and Antimicrobial Properties of Essential Oils of Four Mediterranean Lamiaceae. J. Ethnopharmacol. 1993, 39, 167–170. [Google Scholar] [CrossRef]
- Van Den Broucke, C.O.; Lemli, J.A. Pharmacological and Chemical Investigation of Thyme Liquid Extracts. Planta Med. 1981, 41, 129–135. [Google Scholar] [CrossRef]
- Sijelmassi, A. Les Plantes Médicinales du Maroc, 3rd ed.; Le Fennec: Casablanca, Morocco, 1993. [Google Scholar]
- Ismaili, H.; Tortora, S.; Sosa, S.; Fkih-Tetouani, S.; Ilidrissi, A.; della Loggia, R.; Tubaro, A.; Aquino, R. Topical Anti-inflammatory Activity of Thymus willdenowii. J. Pharm. Pharmacol. 2001, 53, 1645–1652. [Google Scholar] [CrossRef]
- Vila, R. Flavonoids and Further Polyphenols in the Genus Thymus. In Thyme; Medicinal and Aromatic Plants—Industrial Profiles Series; Stahl-Biskup, E., Sáez, F., Eds.; Taylor and Francis: London, UK, 2002; pp. 144–177. [Google Scholar]
- El Idrissi, M.; Idrissi, E.L. Caractérisation Chimique de Certaines Espèces de Thym Marocain Du Moyen Atlas (Région de Khenifra). Sci. Lib. 2014, 6, 140906. [Google Scholar]
- Ainane, A.; Khammour, F.; Charaf, S.; Elabboubi, M.; Bennani, L.; Talbi, M.; Cherroud, S.; Ainane, T. Chemical Composition and Anti-Insecticidal Activity of the Essential Oils of Thymus of Morocco: Thymus capitates, Thymus bleicherianus and Thymus satureioides. Org. Med. Chem. Int. J. 2018, 6, 54–59. [Google Scholar] [CrossRef]
- Moldão-Martins, M.; Bernardo-Gil, G.M.; da Costa, L.M. Sensory and Chemical Evaluation of Thymus zygis L. Essential Oil and Compressed CO2 Extracts. Eur. Food Res. Technol. 2002, 214, 207–211. [Google Scholar] [CrossRef]
- Sotomayor, J.A.; Martínez, R.M.; García, A.J.; Jordán, M.J. Thymus zygis Subsp. Gracilis: Watering Level Effect on Phytomass Production and Essential Oil Quality. J. Agric. Food Chem. 2004, 52, 5418–5424. [Google Scholar] [CrossRef] [PubMed]
- Sotomayor Sánchez, J.A.; Sánchez Gómez, P. Estudio sobre Plantas Aromáticas de los Generos Salvia y Thymus, Espontaneas en el SE Ibérico, para su Establecimiento como Cultivo. Ph.D. Thesis, Universidad de Murcia, Murcia, Spain, 1998. [Google Scholar]
- Jordán, M.J.; Martínez, R.M.; Martínez, C.; Monino, I.; Sotomayor, J.A. Polyphenolic Extract and Essential Oil Quality of Thymus zygis ssp. Gracilis Shrubs Cultivated under Different Watering Levels. Ind. Crops Prod. 2009, 29, 145–153. [Google Scholar] [CrossRef]
- Karousou, R.; Koureas, D.N.; Kokkini, S. Essential Oil Composition Is Related to the Natural Habitats: Coridothymus capitatus and Satureja thymbra in NATURA 2000 Sites of Crete. Phytochemistry 2005, 66, 2668–2673. [Google Scholar] [CrossRef]
- Pluhár, Z.; Héthelyi, É.; Kutta, G.; Kamondy, L. Evaluation of Environmental Factors Influencing Essential Oil Quality of Thymus pannonicus All. and Thymus praecox Opiz. J. Herbs Spices Med. Plants 2007, 13, 23–43. [Google Scholar] [CrossRef]
- Amarti, F.; Satrani, B.; Ghanmi, M.; Farah, A.; Aafi, A.; Aarab, L.; El Ajjouri, M.; Chaouch, A. Composition Chimique et Activité Antimicrobienne Des Huiles Essentielles de Thymus algeriensis Boiss. & Reut. et Thymus ciliatus (Desf.) Benth. Du Maroc. BASE 2010, 14, 141–148. [Google Scholar]
- Cheurfa, M.; Allem, R.; Sebaihia, M.; Belhireche, S. Effet de l’huile Essentielle de Thymus vulgaris Sur Les Bactéries Pathogènes Responsables de Gastroentérites. Phytothérapie 2013, 11, 154–160. [Google Scholar] [CrossRef]
- Moldão-Martins, M.; Bernardo-Gil, M.G.; Beirão da Costa, M.L.; Rouzet, M. Seasonal Variation in Yield and Composition of Thymus Zygis, L. Subsp. Sylvestris Essential Oil. Flavour Fragr. J. 1999, 14, 177–182. [Google Scholar] [CrossRef]
- Gonçalves, M.J.; Cruz, M.T.; Cavaleiro, C.; Lopes, M.C.; Salgueiro, L. Chemical, Antifungal and Cytotoxic Evaluation of the Essential Oil of Thymus zygis subsp. Sylvestris. Ind. Crops Prod. 2010, 32, 70–75. [Google Scholar] [CrossRef]
- Mateo, C.; Morera, M.P.; Sanz, J.; Hernandez, A. ‘Estudio analítico de aceites esenciales procedentes de plantas españolas. 1. Especies del género Thymus. Riv. Ital, EPPOS 1978, 60, 621–627, Ibídem, 1979, 61, 135. [Google Scholar]
- Morales Valverde, R. Taxonomía de Los Géneros Thymus (Excluida de La Sección Serpyllum) y Thymbra En La Península Ibérica; CSIC-Real Jardín Botánico (RJB): Madrid, Spain, 1986; ISBN 8400063201. [Google Scholar]
- Rota, M.C.; Herrera, A.; Martínez, R.M.; Sotomayor, J.A.; Jordán, M.J. Antimicrobial Activity and Chemical Composition of Thymus vulgaris, Thymus zygis and Thymus hyemalis Essential Oils. Food Control 2008, 19, 681–687. [Google Scholar] [CrossRef]
- Velasco, A.; Pérez Alonso, M.J. Aceites Esenciales de Tomillos Ibéricos. III. Contribución al Estudio de Quimiotipos En El Grupo Thymus Zygis. An. Bromatol. 1984, 36, 301–308. [Google Scholar]
- Cabo, J.; Jimenez, J.; Revert, A.; Bravo, L. Influence of Ecological Factors (Altitude) on the Content and Composition of the Essence of Two Samples of Thymus zygis L., [Thyme] Picked in Different Areas. Ars Pharm. 1981, 24, 364. (In Spanish) [Google Scholar]
- Benjilali, B.; Hammoumi, M.; Richard, H. Chemical Polymorphism of Moroccan Thyme Essential Oils. 1. Coumpounds Characterization. Sci. Aliment. 1987, 7, 77–91. [Google Scholar]
- Stahl-Biskup, E. Essential Oil Chemistry of the Genus Thymus—A Global View. In Thyme; CRC Press: Boca Raton, FL, USA, 2002; pp. 89–138. ISBN 0429218656. [Google Scholar]
- Stahl-Biskup, E. The Chemical Composition of Thymus Oils: A Review of the Literature 1960–1989. J. Essent. Oil Res. 1991, 3, 61–82. [Google Scholar] [CrossRef]
- Raal, A.; Paaver, U.; Arak, E.; Orav, A. Content and Composition of the Essential Oil of Thymus serpyllum L. Growing Wild in Estonia. Medicina 2004, 40, 795–800. [Google Scholar] [PubMed]
- Mishra, R.; Gupta, A.K.; Kumar, A.; Lal, R.K.; Saikia, D.; Chanotiya, C.S. Genetic Diversity, Essential Oil Composition, and in Vitro Antioxidant and Antimicrobial Activity of Curcuma Longa, L. Germplasm Collections. J. Appl. Res. Med. Aromat. Plants 2018, 10, 75–84. [Google Scholar] [CrossRef]
- Nguyen, H.T.; Sárosi, S.T.; Llorens-Molina, J.A.; Ladányi, M.; Zámborine-Németh, É. Compositional Variability in Essential Oils of Twelve Wormwood (Artemisia absinthium L.) Accessions Grown in the Same Environment. J. Essent. Oil Res. 2018, 30, 421–430. [Google Scholar] [CrossRef]
- Hudaib, M.; Speroni, E.; Di Pietra, A.M.; Cavrini, V. GC/MS Evaluation of Thyme (Thymus vulgaris L.) Oil Composition and Variations during the Vegetative Cycle. J. Pharm. Biomed. Anal. 2002, 29, 691–700. [Google Scholar] [CrossRef]
- Arraiza, M.P.; Andrés, M.P.; Arrabal, C.; López, J. V Seasonal Variation of Essential Oil Yield and Composition of Thyme (Thymus vulgaris L.) Grown in Castilla—La Mancha (Central Spain). J. Essent. Oil Res. 2009, 21, 360–362. [Google Scholar] [CrossRef]
- Jordán, M.J.; Martínez, R.M.; Goodner, K.L.; Baldwin, E.A.; Sotomayor, J.A. Seasonal Variation of Thymus hyemalis Lange and Spanish Thymus vulgaris L. Essential Oils Composition. Ind. Crop. Prod. 2006, 24, 253–263. [Google Scholar] [CrossRef]
- Aziz, E.E.; Hendawy, S.F. Effect of Soil Type and Irrigation Intervals on Plant Growth, Essential Oil Yield and Constituents of Thymus vulgaris Plant. Am. Eurasian J. Agric. Environ. Sci. 2008, 4, 443–450. [Google Scholar]
- Figueiredo, A.C.; Barroso, J.G.; Pedro, L.G.; Scheffer, J.J. Factors Affecting Secondary Metabolite Production in Plants: Volatile Components and Essential Oils. Flavour Fragr. J. 2008, 23, 213–226. [Google Scholar] [CrossRef]
- Azevedo, N.R.; Campos, I.F.; Ferreira, H.D.; Portes, T.A.; Santos, S.C.; Seraphin, J.C.; Paula, J.R.; Ferri, P.H. Chemical Variability in the Essential Oil of Hyptis suaveolens. Phytochemistry 2001, 57, 733–736. [Google Scholar] [CrossRef]
- Orav, A.; Raal, A.; Arak, E.; Muurisepp, M.; Kailas, T. Composition of the Essential Oil of Artemisia absinthium L. of Different Geographical Origin. Proc. Est. Acad. Sci. Chem. 2006, 55, 155. [Google Scholar]
- Lamaze, T.; Tousch, D.; Sarda, X.; Grignon, C.; Depigny, D.; This, D.; Monneveux, P.; Belhassen, E. Résistance des Plantes à la Sécheresse: Mécanismes Physiologiques. Proc. Journée ASF Assoc. Sélectionneurs Français 1994, 45, 75–85. [Google Scholar]
- Amarti, F.; Satrani, B.; Ghanmi, M.; Aafi, A.; Farah, A.; Aarab, L.; El Ajjouri, M.; Guedira, A.; Chaouch, A. Activité Antioxydante et Composition Chimique Des Huiles Essentielles de Quatre Espèces de Thym Du Maroc. Acta Bot. Gall. 2011, 158, 513–523. [Google Scholar] [CrossRef]
- Dandlen, S.A.; Lima, A.S.; Mendes, M.D.; Miguel, M.G.; Faleiro, M.L.; Sousa, M.J.; Pedro, L.G.; Barroso, J.G.; Figueiredo, A.C. Antioxidant Activity of Six Portuguese Thyme Species Essential Oils. Flavour Fragr. J. 2010, 25, 150–155. [Google Scholar] [CrossRef]
- Bouhdid, S.; Idaomar, M.; Zhiri, A.; Baudoux, D.; Skali, N.S.; Abrini, J. Thymus Essential Oils: Chemical Composition and in Vitro Antioxidant and Antibacterial Activities. In Proceedings of the Congrès International de Biochimie, Agadir, Morocco, 9–12 May 2006; Volume 324, p. 327. [Google Scholar]
- Amaghnouje, A.; Mechchate, H.; Es-Safi, I.; Boukhira, S.S.; Aliqahtani, A.M.; Noman, O.A.; Nasr, F.; Conte, R.; Calarco, A.; Bousta, D. Subacute Assessment of the Toxicity and Antidepressant-Like Effects of Origanum majorana, L. Polyphenols in Swiss Albino Mice. Molecules 2020, 25, 5653. [Google Scholar] [CrossRef]
- Safaei-Ghomi, J.; Ebrahimabadi, A.H.; Djafari-Bidgoli, Z.; Batooli, H. GC/MS Analysis and in Vitro Antioxidant Activity of Essential Oil and Methanol Extracts of Thymus caramanicus Jalas and Its Main Constituent Carvacrol. Food Chem. 2009, 115, 1524–1528. [Google Scholar] [CrossRef]
- Leclercq, R.; Cantón, R.; Brown, D.F.; Giske, C.G.; Heisig, P.; MacGowan, A.P.; Mouton, J.W.; Nordmann, P.; Rodloff, A.C.; Rossolini, G.M. EUCAST Expert Rules in Antimicrobial Susceptibility Testing. Clin. Microbiol. Infect. 2013, 19, 141–160. [Google Scholar] [CrossRef] [PubMed]
- Lahsoune, M.; Boutayeb, H.; Zerouali, K.; Belabbes, H.; El Mdaghri, N. Prévalence et état de sensibilité aux antibiotiques d’Acinetobacter baumannii dans un CHU marocain. Méd. Mal. Infect. 2007, 37, 828–831. [Google Scholar] [CrossRef]
- Berche, P.; Gaillard, J.-L.; Simonet, M.; Simonet, M. Bactériologie: Bactéries des Infections Humaines; Flammarion Médecine-Sciences: Paris, France, 1988; ISBN 2-257-10489-7. [Google Scholar]
- Percival, S.L.; Chalmers, R.; Embrey, M.; Hunter, P.R.; Sellwood, J.; Wyn-Jones, P. Microbiology of Waterborne Diseases; Elsevier Academic Press: London, UK, 2004; ISBN 0-12-551570-7. [Google Scholar]
- Zhao, Q.; Jia, X.; Pang, F.; Li, Y. Study on Genotype and Clinical Characteristics of Infection of Carbapenemase-Producing Enterobacter Cloacae. Zhonghua Yi Xue Za Zhi 2015, 95, 3264–3268. [Google Scholar]
- Arshad, R.; Pal, K.; Sabir, F.; Rahdar, A.; Bilal, M.; Shahnaz, G.; Kyzas, G.Z. A Review of the Nanomaterials Use for the Diagnosis and Therapy of salmonella typhi. J. Mol. Struct. 2021, 1230, 129928. [Google Scholar] [CrossRef]
- World Health Organization. Directives pour la Lutte Contre la Shigellose, y Compris Lors d’Épidémies Dues à Shigella Dysenteriae Type 1; World Health Organization: Geneva, Switzerland, 2008. [Google Scholar]
- Baudoux, D. Aromatherapy: Healing with Essential Oils; (Douce Alternative); Les Éditions Amyris: Bruxelles, Belgium, 2016. [Google Scholar]
- Saǧdιç, O. Sensitivity of Four Pathogenic Bacteria to Turkish Thyme and Oregano Hydrosols. LWT Food Sci. Technol. 2003, 36, 467–473. [Google Scholar] [CrossRef]
- Dorman, H.; Deans, S.G. Antimicrobial Agents from Plants: Antibacterial Activity of Plant Volatile Oils. J. Appl. Microbiol. 2000, 88, 308–316. [Google Scholar] [CrossRef] [PubMed]
- Oussalah, M.; Caillet, S.; Saucier, L.; Lacroix, M. Antimicrobial Effects of Selected Plant Essential Oils on the Growth of a Pseudomonas Putida Strain Isolated from Meat. Meat Sci. 2006, 73, 236–244. [Google Scholar] [CrossRef]
- Moleyar, V.; Narasimham, P. Antibacterial Activity of Essential Oil Components. Int. J. Food Microbiol. 1992, 16, 337–342. [Google Scholar] [CrossRef]
- Kalemba, D.; Kunicka, A. Antibacterial and Antifungal Properties of Essential Oils. Curr. Med. Chem. 2003, 10, 813–829. [Google Scholar] [CrossRef]
- Filippi, J.-J.; Lanfranchi, D.-A.; Prado, S.; Baldovini, N.; Meierhenrich, U.J. Composition, Enantiomeric Distribution, and Antibacterial Activity of the Essential Oil of Achillea Ligustica All. from Corsica. J. Agric. Food Chem. 2006, 54, 6308–6313. [Google Scholar] [CrossRef]
- Lawrence, B.M.; Hogg, J.W.; Terhune, S.J.; Pichitakul, N. Essential Oils and Their Constituents. IX. The Oils of Ocimum sanctum and Ocimum basilicum from Thailand. Flavour Ind. 1972, 3, 47–49. [Google Scholar]
- Piens, M.A.; De Monbrison, F.; Picot, S. Étude de La Sensibilité Des Levures Aux Antifongiques En Pratique Médicale. Lett. Infect. 2003, 2003, 222–226. [Google Scholar]
- Espinel-Ingroff, A.; Dawson, K.; Pfaller, M.; Anaissie, E.; Breslin, B.; Dixon, D.; Fothergill, A.; Paetznick, V.; Peter, J.; Rinaldi, M. Comparative and Collaborative Evaluation of Standardization of Antifungal Susceptibility Testing for Filamentous Fungi. Antimicrob. Agents Chemother. 1995, 39, 314–319. [Google Scholar] [CrossRef]
- Debourgogne, A. Fusarium Solani, Typage Moléculaire et Mécanisme d’Adaptation à Son Environnement. Ph.D. Thesis, Université de Lorraine, Lorraine, France, 2021. [Google Scholar]
- Bellakhdar, J. Pharmacopée Marocaine Traditionnelle; Ibis Press: Paris, France, 1997; ISBN 291072803X. [Google Scholar]
- Ponce, A.G.; Fritz, R.; Del Valle, C.; Roura, S.I. Antimicrobial Activity of Essential Oils on the Native Microflora of Organic Swiss Chard. LWT Food Sci. Technol. 2003, 36, 679–684. [Google Scholar] [CrossRef]
- Meena, M.F. Antimicrobial Activity of Essential Oils from Spices. J. Food Sci. Technol. 1994, 31, 68–70. [Google Scholar]
- Ultee, A.; Slump, R.A.; Steging, G.; Smid, E.J. Antimicrobial Activity of Carvacrol toward Bacillus Cereus on Rice. J. Food Prot. 2000, 63, 620–624. [Google Scholar] [CrossRef] [PubMed]
- Ettayebi, K.; El Yamani, J.; Rossi-Hassani, B.-D. Synergistic Effects of Nisin and Thymol on Antimicrobial Activities in Listeria monocytogenes and Bacillus subtilis. FEMS Microbiol. Lett. 2000, 183, 191–195. [Google Scholar] [CrossRef] [PubMed]
- Bakkali, F.; Averbeck, S.; Averbeck, D.; Idaomar, M. Biological Effects of Essential Oils–A Review. Food Chem. Toxicol. 2008, 46, 446–475. [Google Scholar] [CrossRef]
- Bazaka, K.; Jacob, M.V.; Chrzanowski, W.; Ostrikov, K. Anti-Bacterial Surfaces: Natural Agents, Mechanisms of Action, and Plasma Surface Modification. RSC Adv. 2015, 5, 48739–48759. [Google Scholar] [CrossRef]
- Durães, F.; Pinto, M.; Sousa, E. Medicinal Chemistry Updates on Bacterial Efflux Pump Modulators. Curr. Med. Chem. 2018, 25, 6030–6069. [Google Scholar] [CrossRef]
- Clevenger, J.F. Apparatus for the Determination of Volatile Oil. J. Am. Pharm. Assoc. 1928, 17, 345–349. [Google Scholar] [CrossRef]
- Adams, R.P. Identification of Essential Oil Components by Gas Chromatography/Mass Spectrometry; Allured Publishing Corporation: Carol Stream, IL, USA, 2007; Volume 456. [Google Scholar]
- Kovats, E.S. Gas Chromatographic Characterization of Organic Substances in the Retention Index System. Adv. Chromatogr. 1965, 1, 229–247. [Google Scholar]
- National Institute of Standards and Technology. Recherche des Données D’espèce par le Nom Chimique. Available online: http://webbook.nist.gov/chemistry (accessed on 15 July 2021).
- Bouhrim, M.; Daoudi, N.E.; Ouassou, H.; Benoutman, A.; Loukili, E.H.; Ziyyat, A.; Mekhfi, H.; Legssyer, A.; Aziz, M.; Bnouham, M. Phenolic Content and Antioxidant, Antihyperlipidemic, and Antidiabetogenic Effects of Opuntia Dillenii Seed Oil. Sci. World J. 2020, 2020, 5717052. [Google Scholar] [CrossRef]
- Zovko Končić, M.; Kremer, D.; Karlović, K.; Kosalec, I. Evaluation of Antioxidant Activities and Phenolic Content of Berberis vulgaris L. and Berberis Croatica Horvat. Food Chem. Toxicol. 2010, 48, 2176–2180. [Google Scholar] [CrossRef]
- Lass-Flörl, C.; Cuenca-Estrella, M.; Denning, D.W.; Rodriguez-Tudela, J.L. Antifungal Susceptibility Testing in Aspergillus spp. According to EUCAST Methodology. Med. Mycol. 2006, 44, S319–S325. [Google Scholar] [CrossRef][Green Version]
- Mohammed, B.; Said, C.; Fouzia, F.R.; Kawtar, F.B.; Zoubida, H.; Abdelilah, O.; Mohammed, E.; Ghizlane, E. Chemical Composition and Antimicrobial Activity of the Essential Oil of Cistus Ladanifer Var. Maculatus Dun. J. Microbiol. Biotechnol. Food Sci. 2021, 2021, 925–930. [Google Scholar]
- El Karkouri, J.; Bouhrim, M.; Al Kamaly, O.M.; Mechchate, H.; Kchibale, A.; Adadi, I.; Amine, S.; Alaoui Ismaili, S.; Zair, T. Chemical Composition, Antibacterial and Antifungal Activity of the Essential Oil from Cistus ladanifer L. Plants 2021, 10, 2068. [Google Scholar] [CrossRef] [PubMed]

| Harvest Site | EO | Yield (%) |
|---|---|---|
| Azrou | T. zygis | 5.25 ± 0.01 |
| Ifrane | T. willdenowii | 3.00 ± 0.02 |
| T. zygis | T. willdenowii | |
|---|---|---|
| Density | 0.92 ± 0.05 | 0.91 ± 0.05 |
| Refractive index | 1.50 ± 0.05 | 1.33 ± 0.04 |
| Degree degree (%) | 85.44 ± 0.05 | 76.62 ± 0.05 |
| No. | Compounds | Kováts Index (KI) | Molecular Formula | Area% | |
|---|---|---|---|---|---|
| T. willdenowii | T. zygis | ||||
| 1 | α-Pinene | 939 | C10H16 | 0.59 | 0.62 |
| 2 | Camphene | 954 | C10H16 | 0.96 | 0.78 |
| 3 | β-Pinene | 979 | C10H16 | - | 0.06 |
| 4 | 1-Octen-3-ol | 979 | C8H16O | - | 0.20 |
| 5 | Myrcene | 990 | C10H16 | 2.43 | 0.27 |
| 6 | 3-δ-Carene | 1002 | C10H16 | - | 0.29 |
| 7 | p-Cymene | 1024 | C10H14 | 1.78 | - |
| 8 | o-Cymene | 1026 | C10H14 | - | 23.14 |
| 9 | Limonene | 1029 | C10H16 | 2.16 | 0.28 |
| 10 | 1,8-Cineole | 1031 | C10H18O | 1.77 | 0.18 |
| 11 | (Z)-β-ocimene | 1037 | C10H16 | 0.42 | - |
| 12 | γ-Terpinene | 1059 | C10H16 | 0.61 | 1.98 |
| 13 | Cis-Linalool oxide | 1072 | C10H18O2 | - | 0.13 |
| 14 | Trans-Linalool oxide | 1086 | C10H18O2 | - | 0.25 |
| 15 | Linalool | 1096 | C10H18O2 | 1.78 | 2.40 |
| 16 | Camphor | 1146 | C10H16O2 | 5.99 | 0.16 |
| 17 | Borneol | 1169 | C10H18O | 4.74 | 3.30 |
| 18 | Terpinen-4-ol | 1177 | C10H18O | 1.06 | 0.35 |
| 19 | α-Terpineol | 1188 | C10H18O | - | 0.10 |
| 20 | Pulegone | 1237 | C10H16O | - | 0.08 |
| 21 | Carvacrol methyl ether | 1244 | C10H16O | - | 0.07 |
| 22 | Thymol | 1290 | C10H14O | 1.28 | 9.68 |
| 23 | Carvacrol | 1299 | C10H14O | 16.19 | 52.2 |
| 24 | Geranyl acetate | 1381 | C12H20O2 | 8.35 | - |
| 25 | β-Bourbonene | 1388 | C15H24 | 2.48 | - |
| 26 | β-Elemene | 1390 | C15H24 | 3.96 | - |
| 27 | (E)-Caryophyllene | 1419 | C15H24 | 5.59 | 0.99 |
| 28 | β-YLangene | 1420 | C15H24 | 0.51 | - |
| 29 | γ-Elemene | 1436 | C15H24 | 0.82 | - |
| 30 | Germacrene D | 1481 | C15H24 | 16.51 | - |
| 31 | α-Murolene | 1500 | C15H24 | - | 0.09 |
| 32 | γ-Amorphene | 1512 | C15H24 | 0.87 | 0.07 |
| 33 | γ-Cadinene | 1513 | C15H24 | 0.87 | - |
| 34 | Spathulenol | 1578 | C15H24O | 0.96 | 0.18 |
| 35 | Caryophyllene oxide | 1583 | C15H24O | 6.90 | 1.06 |
| 36 | Allo-Aromadendrene epoxide | 1640 | C15H24O | 0.92 | - |
| 37 | Caryophylla-4(12),8(13)-dien-5β-ol | 1640 | C15H24O | - | 0.09 |
| 38 | Epi-α-Cadinol | 1640 | C15H26O | - | 0.09 |
| 39 | Cubenol | 1646 | C15H26O | 0.55 | - |
| 40 | Eudesmol | 1650 | C15H26O | 0.61 | - |
| 41 | Cedr-8(15)-en-10-ol | 1652 | C15H24O | - | 0.20 |
| 42 | α-Cadinol | 1654 | C15H18 | 1.32 | - |
| 43 | Cadalene | 1676 | C15H18 | - | 0.23 |
| 44 | Germacra-4(15),5,10(14)-trien-1α-ol | 1686 | C15H24O | 2.09 | - |
| 45 | hexahydrofarnesyl acetone | 1932 | C18H36O | 0.62 | - |
| 46 | Cembrene C | 1940 | C20H18 | 0.69 | - |
| 47 | Hexadecanoic acid | 1960 | C16H32O2 | 2.31 | - |
| 48 | Cis-Totarol, methyl ether | 2208 | C21H32O | - | 0.07 |
| Oxygenated monoterpenes | 32.81 | 68.7 | |||
| Hydrocarbon monoterpenes | 8.95 | 27.55 | |||
| Hydrocarboned sesquiterpene | 31.61 | 1.4 | |||
| Oxygenated sesquiterpene | 13.35 | 1.85 | |||
| Lignar esters | 8.35 | - | |||
| Others | 3.62 | 0.27 | |||
| Total | 98.69 | 99.84 | |||
| ATB | A. baumannii | ATB | E. cloacae |
|---|---|---|---|
| TIC75 | 6 ± 00 (R) | TIC75 | 6 ± 00 (R) |
| CAZ30 | 6 ± 00 (R) | CAZ30 | 20 ± 00 (S) |
| MEM10 | 6 ± 00 (R) | OFX5 | 6 ± 00 (R) |
| TIM85 | 6 ± 00 (R) | AMC3 | 6 ± 00 (R) |
| IPM10 | 6 ± 00 (R) | IPM10 | 27 ± 0.1 (S) |
| CT50 | 6 ± 00 (R) | CT50 | 6 ± 00 (R) |
| TOB10 | 6 ± 00 (R) | FOX30 | 21 ± 00 (S) |
| CIP5 | 6 ± 00 (R) | AML10 | 6 ± 00 (R) |
| TE30 | 6 ± 00 (R) | CN15 | 22 ± 0.2 (S) |
| CN15 | 21.5 ± 0.1 (S) | AK30 | 19 ± 00 (I) |
| AK30 | 6 ± 00 (R) | ||
| PRL75 | 6 ± 00 (R) |
| ATB | S. aureus | ATB | E. coli | S. Typhi | S. dysenteriae |
|---|---|---|---|---|---|
| CIP5 | 23 ± 0.1 (S) | CT50 | 20 ± 0.1 (S) | 20 ± 0.1 (S) | 21 ± 0.2 (S) |
| VA30 | 26 ± 0.3 (S) | MEM10 | 21 ± 0.2 (S) | 22 ± 0.2 (S) | 23.5 ± 0.1 (S) |
| TE30 | 24.5 ± 0.2 (S) | TIC75 | 06 ± 00 (R) | 21.5 ± 00 (S) | 20.5 ± 0.3 (S) |
| CN15 | 21 ± 0.1 (S) | AK30 | 20 ± 0.1 (S) | 22 ± 0.2 (S) | 22 ± 0.1 (S) |
| MY15 | 30 ± 0.1 (S) | C30 | 27 ± 00 (S) | 29 ± 00 (S) | 20 ± 00 (S) |
| E15 | 20 ± 00 (S) | PRL75 | 21 ± 00 (S) | 21 ± 00 (S) | 21 ± 00 (S) |
| CAZ30 | 22 ± 0.3 (S) | IPM10 | 23 ± 0.2 (S) | 21 ± 0.3 (S) | 23 ± 0.2 (S) |
| TOB10 | 21.5 ± 0.1 (S) | CIP5 | 20 ± 0.1 (S) | 20.5 ± 0.2 (S) | 30.5 ± 0.1 (S) |
| SXT25 | 20 ± 0.2 (S) | AMC30 | 21 ± 0.2 (S) | 21 ± 0.1 (S) | 20 ± 0.2 (S) |
| FD10 | 23 ± 0.4 (S) | CN15 | 06 ± 00 (R) | 20 ± 0.2 (S) | 21 ± 0.1 (S) |
| FOX30 | 22 ± 0.1 (S) | CAZ30 | 20 ± 0.1 (S) | 23.5 ± 0.1 (S) | 20.5 ± 0.2 (S) |
| RD30 | 25 ± 00 (S) | CRO30 | 21 ± 00 (S) | 22 ± 00 (S) | 24 ± 00 (S) |
| OFX5 | 20 ± 0.1 (S) | CTX30 | 20 ± 0.2 (S) | 21 ± 0.1 (S) | 23 ± 0.2 (S) |
| Essential Oils Concentration Tested (µL/mL) | Essential Oils Inhibition Diameter (mm) | |||||||||||
|---|---|---|---|---|---|---|---|---|---|---|---|---|
| S. aureus | E. coli | S. Typhi | A. baumannii | E.cloacae | S. dysenteriae | |||||||
| Tz | Tw | Tz | Tw | Tz | Tw | Tz | Tw | Tz | Tw | Tz | Tw | |
| 2 | 75 ± 00 *** | 33 ± 0.2 *** | 54 ± 00 *** | 15 ± 00 ns | 20 ± 00 * | 06 ± 00 ns | 71.5 ± 0.1 *** | 30 ± 00 ** | 60.1 ± 0.1 *** | 14 ± 00 ns | 6 ± 00 ns | 6 ± 00 ns |
| 4 | 84 ± 0.2 *** | 33.8 ± 0.1 *** | 60 ± 00 *** | 16.3 ± 0.1 ns | 24.5 ± 0.3 * | 6 ± 00 ns | 72 ± 00 *** | 35 ± 00 ** | 64.5 ± 0.4 *** | 15.5 ± 1.2 ns | 18 ± 0.1 ns | 6 ± 00 ns |
| 6 | 84 ± 0.1 *** | 38 ± 0.3 *** | 71 ± 00 *** | 18 ± 00 * | 30.1 ± 0.2 ** | 13.5 ± 0.1 ns | 76.3 ± 0.2 *** | 43.6 ± 0.1 *** | 71.3 ± 0.3 *** | 21 ± 00 * | 37.5 ± 0.9 ** | 6 ± 00 ns |
| 8 | 84 ± 0.6 *** | 42 ± 00 *** | 82.2 ± 0.2 *** | 21.4 ± 0.2 * | 50 ± 00 *** | 16 ± 00 ns | 78.1 ± 0.1 *** | 51 ± 00 *** | 77 ± 00 *** | 23 ± 00 * | 40 ± 00 *** | 13 ± 00 ns |
| 10 | 84 ± 0.3 *** | 47.2 ± 0.1 *** | 84 ± 00 *** | 22.1 ± 0.3 * | 52 ± 00 *** | 18.9 ± 1.3* | 80.7 ± 1.4 *** | 56 ± 00 *** | 78.9 ± 0.1 *** | 35 ± 00 * | 48.6 ± 0.4 *** | 15 ± 00 ns |
| 12 | 84 ± 00 *** | 48 ± 00 *** | 84 ± 00 *** | 23 ± 00 * | 57.5 ± 00 *** | 23 ± 00 * | 81 ± 00 *** | 60 ± 00 *** | 82 ± 00 *** | 38 ± 00 * | 51 ± 00 *** | 18 ± 00 * |
| 2(DMSO) | 06 ± 00 | 06 ± 00 | 06 ± 00 *** | 06 ± 00 | 06 ± 00 | 06 ± 00 | 06 ± 00 | 06 ± 00 | 06 ± 00 | 06 ± 00 | 06 ± 00 | 06 ± 00 |
| Bacteria | T. zygis | T. willdenowii | ||
|---|---|---|---|---|
| MIC µL/mL | MBC µL/mL | MIC µL/mL | MBC µL/mL | |
| E. coli | 02 ± 0.002 * | 02 ± 0.001 * | 04 ± 0.006 * | 04 ± 00 ns |
| S. aureus | 02 ± 0.0009 * | 02 ± 0.004 * | 04 ± 00 ns | 04 ± 0.01 ** |
| S. Typhi | 04 ± 0.003 * | 04 ± 00 ns | 06 ± 00 ns | 06 ± 00 ns |
| A. baumannii | 02 ± 0.001 * | 02 ± 0.001 * | 04 ± 0.001 * | 04 ± 0.012 ** |
| E. cloacae | 02 ± 0.007 * | 02 ± 00 ns | 06 ± 0.008* | 06 ± 0.005 * |
| S. dysenteriae | 06 ± 0.0001 * | 06 ± 0.0003 * | 10 ± 00 ns | 10 ± 00 ns |
| Fungal Species | Antifungal: Fluconazole V = 20 µL |
|---|---|
| C. glabrata | S |
| C. albicans | S |
| Candida spp. | R |
| A. fischeri | R |
| F. solani | R |
| Species | C = 20 µL/mL | ||||
|---|---|---|---|---|---|
| Volatile Oil Inhibition Diameter (mm) | |||||
| C. glabrata | C. albicans | Candida spp. | F. solani | A. fischeri | |
| T. zygis | 40 ± 0.3 * | 29 ± 0.5 ns | 27 ± 1.2 ns | 18 ± 1.3 ns | 40 ± 2.1 ** |
| T. willdenowii | 17 ± 0.1 ns | 19 ± 1.1 ns | 23 ± 0.1 ns | 12 ± 00 ns | 22 ± 00 * |
| Fluconazole | 24.7 ± 0.1 | 23.7 ± 0.2 | 24 ± 0.6 | 16.3 ± 0.3 | 13.7 ± 02 |
| Fungal Species | T. zygis | T. willdenowii | ||||
|---|---|---|---|---|---|---|
| MIC µL/mL | MFC µL/mL | MFC/MIC | MFC µL/mL | MFC µL/mL | MFC/MIC | |
| C. glabrata | 20 ± 0.001 * | 20 ± 0.0009 * | 1 | 30 ± 00 ns | 30 ± 00 ns | 1 |
| C. albicans | 20 ± 0.015 ** | 20 ± 0.0001 * | 1 | 20 ± 0.0009 * | 20 ± 00 ns | 1 |
| Candida spp. | 20 ± 00 ns | 20 ± 00 ns | 1 | 20 ± 0.002 * | 20 ± 0.007 * | 1 |
| F. solani | 30 ± 00 ns | 30 ± 0.0002 * | 1 | 30 ± 00 ns | 30 ± 00 ns | 1 |
| A. fischeri | 20 ± 0.014 ** | 20 ± 00 ns | 1 | 20 ± 00 ns | 20 ± 00 ns | 1 |
Publisher’s Note: MDPI stays neutral with regard to jurisdictional claims in published maps and institutional affiliations. |
© 2021 by the authors. Licensee MDPI, Basel, Switzerland. This article is an open access article distributed under the terms and conditions of the Creative Commons Attribution (CC BY) license (https://creativecommons.org/licenses/by/4.0/).
Share and Cite
Radi, F.z.; Bouhrim, M.; Mechchate, H.; Al-zahrani, M.; Qurtam, A.A.; Aleissa, A.M.; Drioiche, A.; Handaq, N.; Zair, T. Phytochemical Analysis, Antimicrobial and Antioxidant Properties of Thymus zygis L. and Thymus willdenowii Boiss. Essential Oils. Plants 2022, 11, 15. https://doi.org/10.3390/plants11010015
Radi Fz, Bouhrim M, Mechchate H, Al-zahrani M, Qurtam AA, Aleissa AM, Drioiche A, Handaq N, Zair T. Phytochemical Analysis, Antimicrobial and Antioxidant Properties of Thymus zygis L. and Thymus willdenowii Boiss. Essential Oils. Plants. 2022; 11(1):15. https://doi.org/10.3390/plants11010015
Chicago/Turabian StyleRadi, Fatima zahrae, Mohamed Bouhrim, Hamza Mechchate, Mohammed Al-zahrani, Ashraf Ahmed Qurtam, Abdulmalik M. Aleissa, Aziz Drioiche, Nadia Handaq, and Touriya Zair. 2022. "Phytochemical Analysis, Antimicrobial and Antioxidant Properties of Thymus zygis L. and Thymus willdenowii Boiss. Essential Oils" Plants 11, no. 1: 15. https://doi.org/10.3390/plants11010015
APA StyleRadi, F. z., Bouhrim, M., Mechchate, H., Al-zahrani, M., Qurtam, A. A., Aleissa, A. M., Drioiche, A., Handaq, N., & Zair, T. (2022). Phytochemical Analysis, Antimicrobial and Antioxidant Properties of Thymus zygis L. and Thymus willdenowii Boiss. Essential Oils. Plants, 11(1), 15. https://doi.org/10.3390/plants11010015

